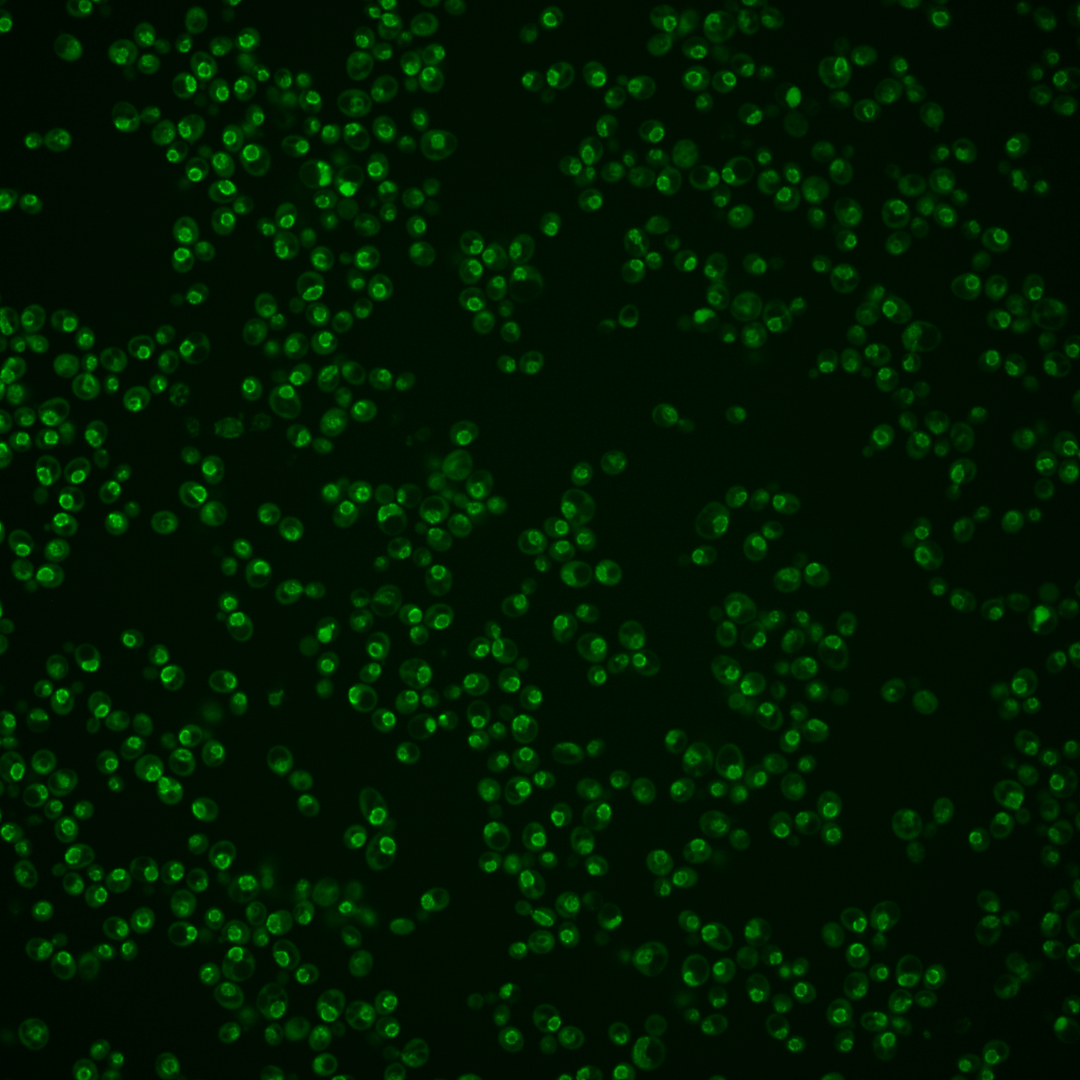
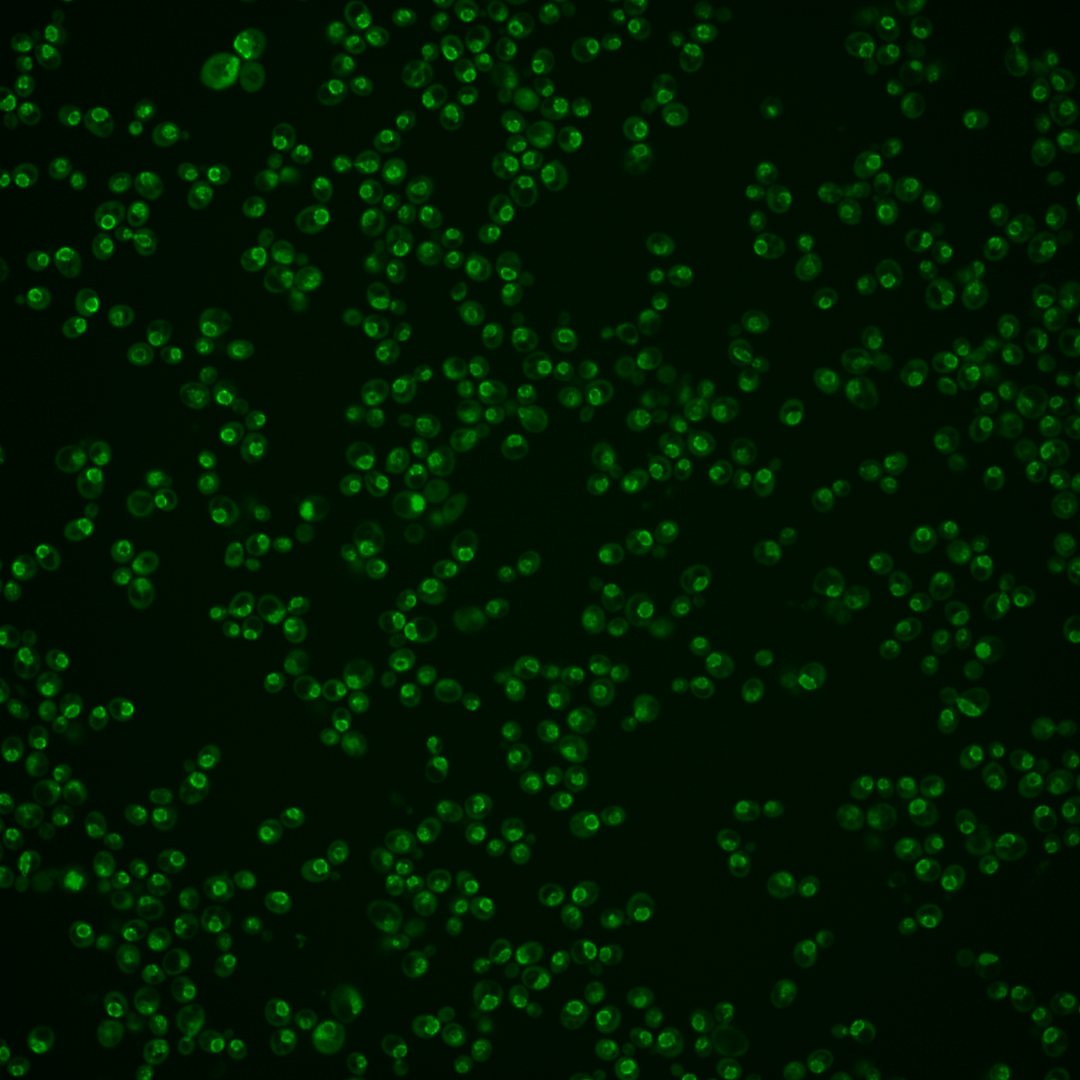
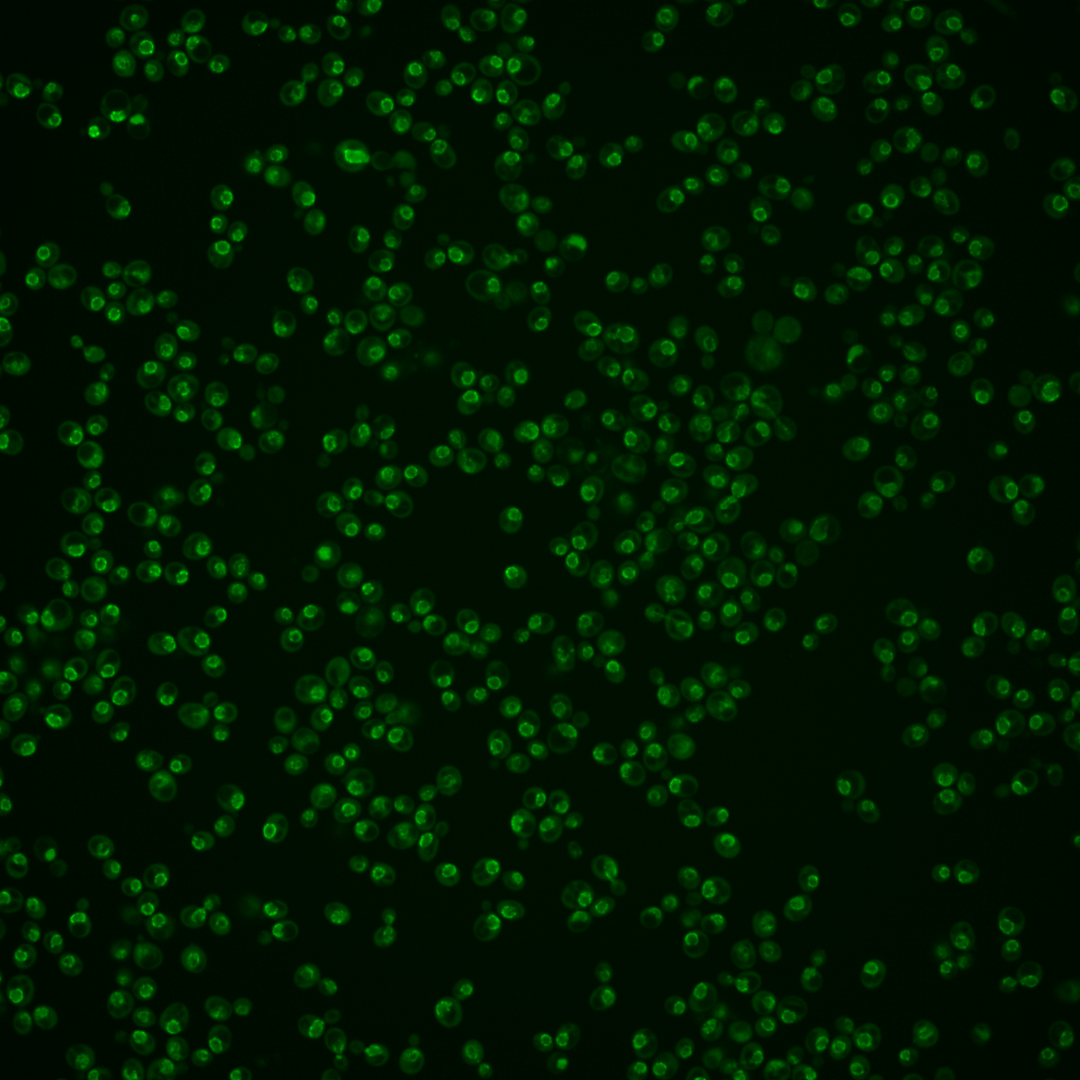
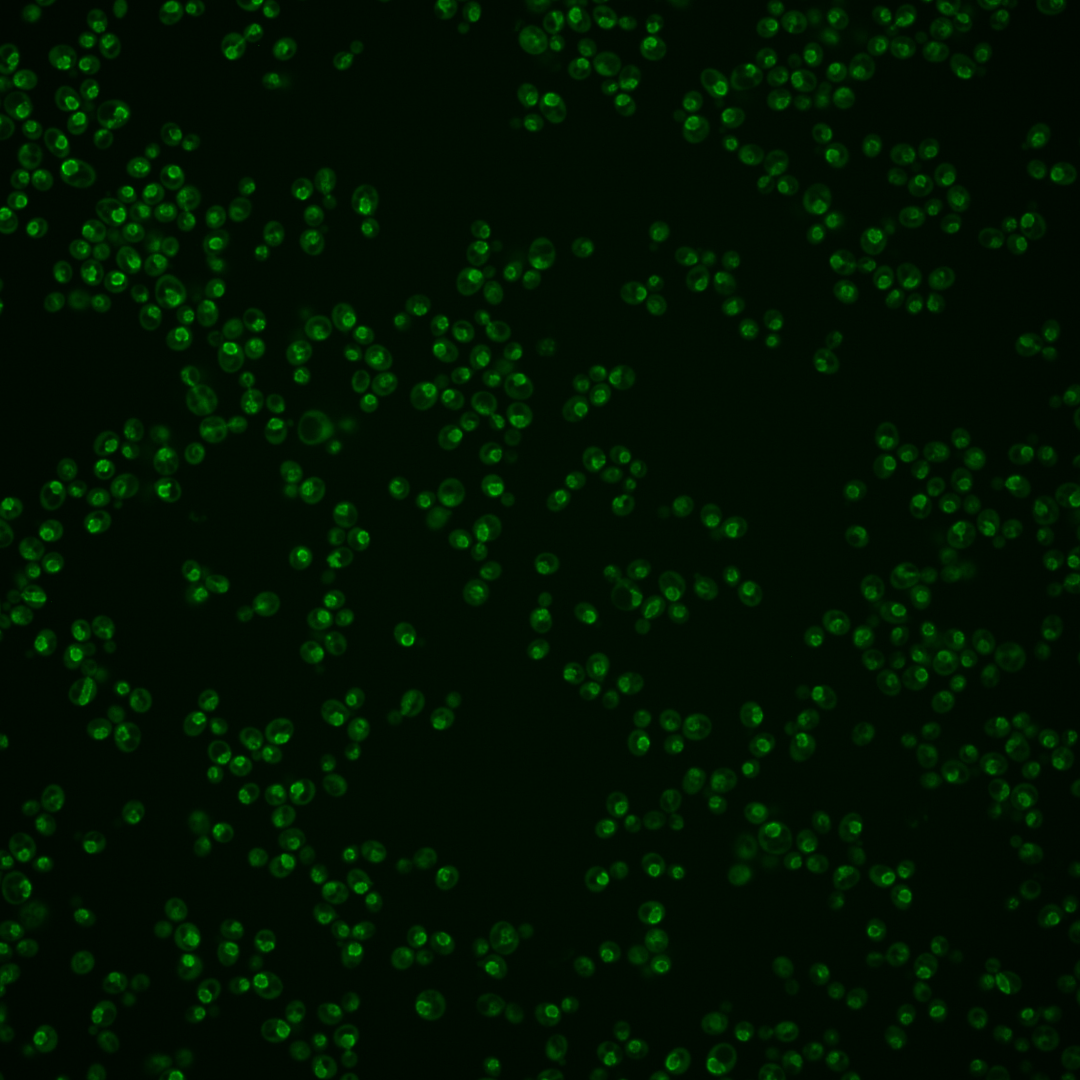
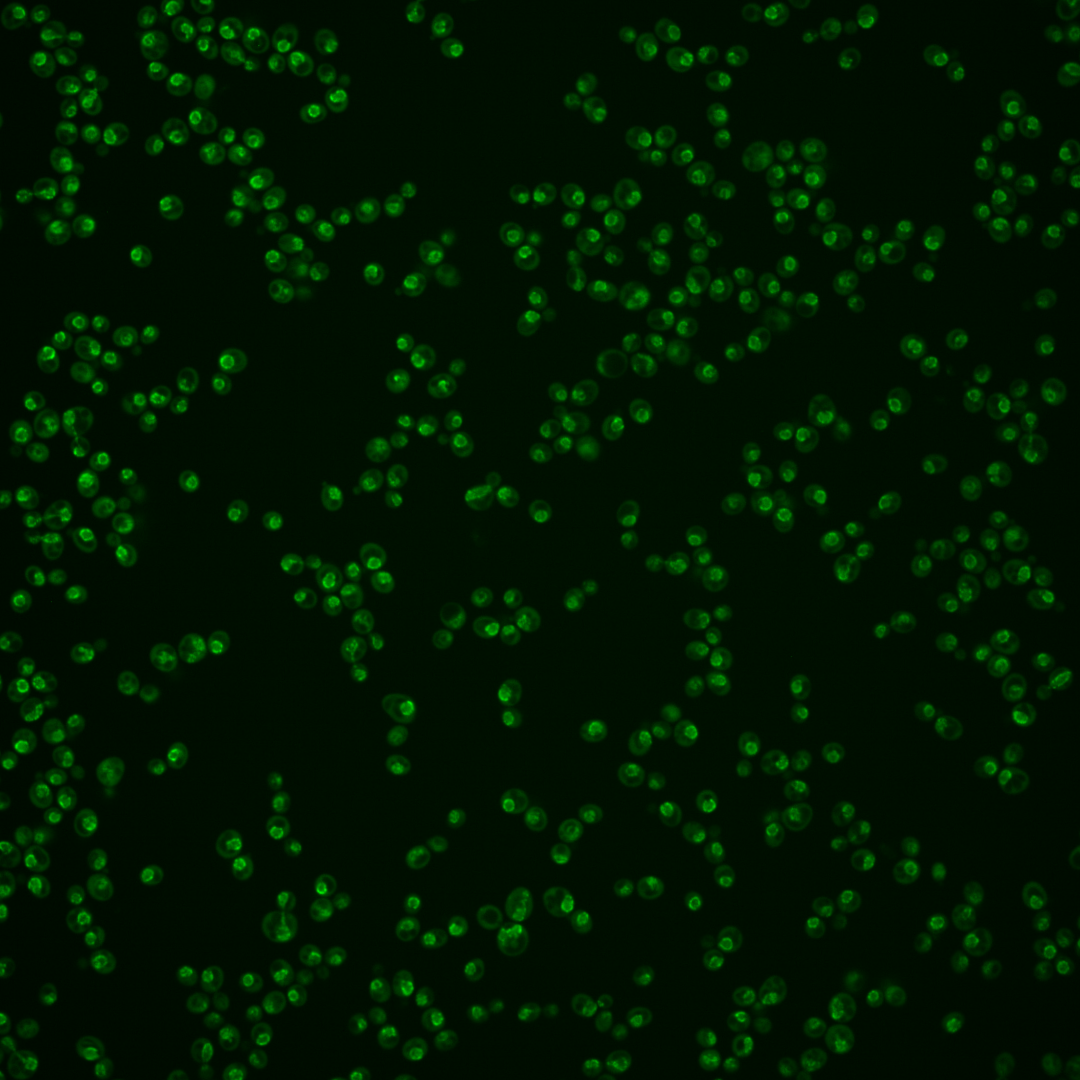
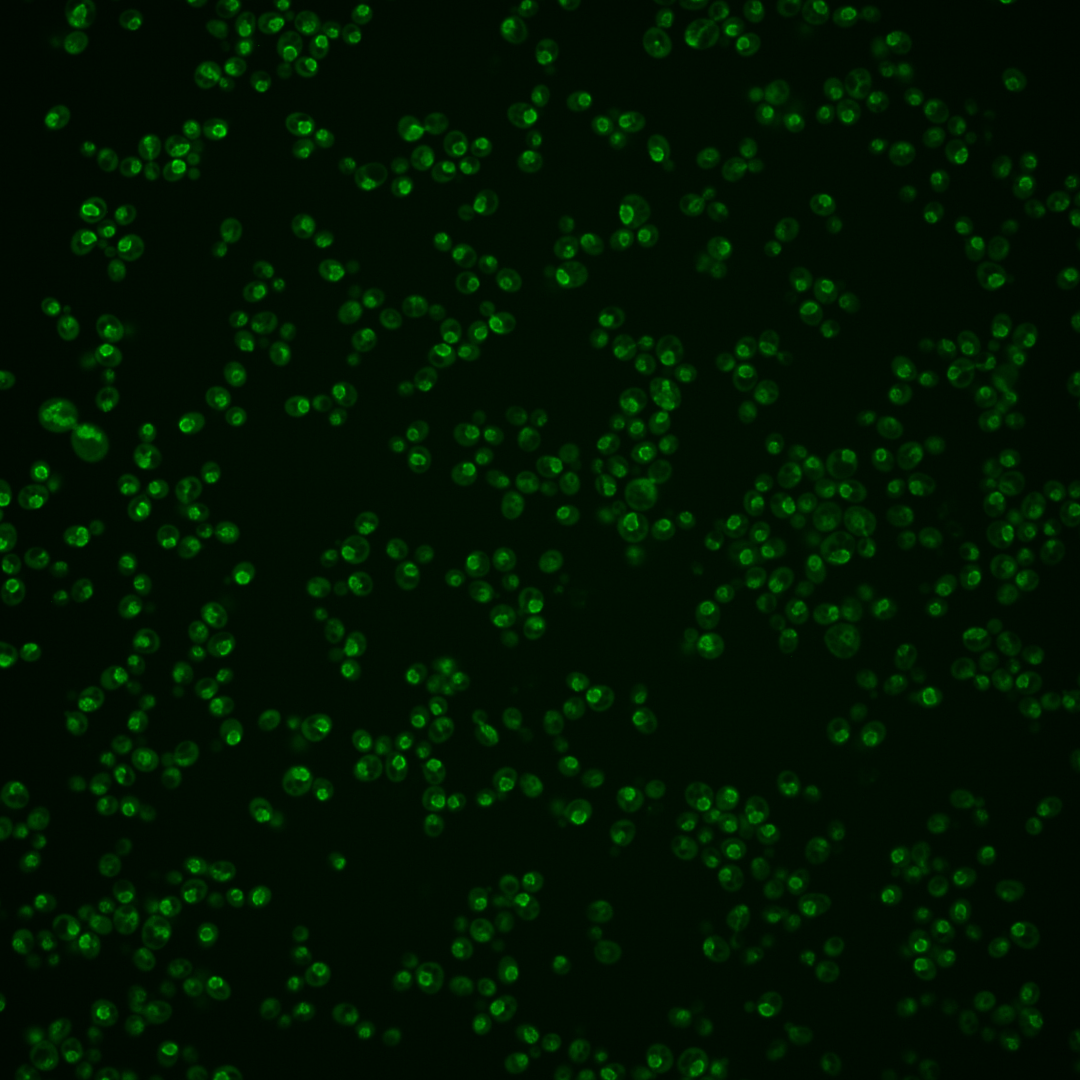

| Standard name | |
|---|---|
| Human Ortholog | |
| Description | Poly(A)RNA binding protein involved in nuclear mRNA export; component of the nuclear pore; ortholog of human TAP |
Micrographs




















































































Sub-cellular Localization
Yeast GFP Assignment
Protein Abundance
Localization Change
External localization resources
| ensLOC | DeepLoc | |||||||||||||||||||||||
|---|---|---|---|---|---|---|---|---|---|---|---|---|---|---|---|---|---|---|---|---|---|---|---|---|
| Localization | WT1 | WT2 | WT3 | RAP60 | RAP140 | RAP220 | RAP300 | RAP380 | RAP460 | RAP540 | RAP620 | RAP700 | HU80 | HU120 | HU160 | rpd3Δ_1 | rpd3Δ_2 | rpd3Δ_3 | WT1 | WT2 | WT3 | AF100 | AF140 | AF180 |
| Cortical Patches | 1 | 2 | 0 | 0 | 3 | 0 | 0 | 0 | 0 | 1 | 0 | 0 | – | – | – | 1 | 3 | 0 | 1 | 1 | 0 | 0 | 0 | 0 |
| Bud | 1 | 1 | 0 | 0 | 0 | 0 | 0 | 2 | 0 | 1 | 0 | 5 | – | – | – | 0 | 1 | 0 | 2 | 8 | 3 | 0 | 0 | 1 |
| Bud Neck | 0 | 0 | 0 | 0 | 0 | 0 | 0 | 0 | 0 | 0 | 0 | 0 | – | – | – | 0 | 0 | 0 | 0 | 0 | 0 | 0 | 0 | 0 |
| Bud Site | 0 | 0 | 0 | 0 | 0 | 0 | 0 | 0 | 1 | 1 | 1 | 1 | – | – | – | 0 | 0 | 0 | – | – | – | – | – | – |
| Cell Periphery | 0 | 0 | 0 | 0 | 0 | 0 | 0 | 0 | 0 | 0 | 0 | 0 | – | – | – | 0 | 0 | 1 | 0 | 0 | 0 | 0 | 0 | 0 |
| Cytoplasm | 2 | 9 | 10 | 6 | 11 | 14 | 16 | 19 | 4 | 5 | 4 | 8 | – | – | – | 13 | 7 | 7 | 0 | 1 | 1 | 0 | 0 | 1 |
| Endoplasmic Reticulum | 5 | 0 | 0 | 4 | 5 | 7 | 8 | 4 | 1 | 2 | 3 | 3 | – | – | – | 5 | 6 | 3 | 2 | 3 | 1 | 0 | 0 | 1 |
| Endosome | 5 | 2 | 2 | 3 | 2 | 14 | 21 | 16 | 3 | 8 | 3 | 17 | – | – | – | 6 | 3 | 6 | 7 | 17 | 5 | 0 | 0 | 1 |
| Golgi | 1 | 16 | 0 | 1 | 7 | 2 | 2 | 2 | 1 | 0 | 0 | 0 | – | – | – | 7 | 14 | 11 | 3 | 2 | 0 | 0 | 0 | 0 |
| Mitochondria | 6 | 3 | 0 | 2 | 2 | 11 | 13 | 9 | 27 | 27 | 74 | 69 | – | – | – | 7 | 8 | 6 | 0 | 1 | 0 | 0 | 0 | 1 |
| Nucleus | 2 | 3 | 5 | 2 | 2 | 5 | 6 | 25 | 5 | 8 | 9 | 20 | – | – | – | 3 | 3 | 1 | 3 | 15 | 4 | 0 | 0 | 0 |
| Nuclear Periphery | 108 | 76 | 18 | 43 | 70 | 61 | 87 | 67 | 48 | 66 | 71 | 103 | – | – | – | 24 | 38 | 24 | 194 | 285 | 81 | 0 | 3 | 7 |
| Nucleolus | 15 | 5 | 2 | 2 | 5 | 15 | 13 | 22 | 28 | 26 | 31 | 40 | – | – | – | 6 | 9 | 5 | 1 | 7 | 1 | 0 | 0 | 0 |
| Peroxisomes | 0 | 0 | 0 | 0 | 0 | 0 | 0 | 0 | 0 | 0 | 1 | 0 | – | – | – | 0 | 0 | 0 | 0 | 0 | 0 | 0 | 0 | 0 |
| SpindlePole | 1 | 0 | 0 | 0 | 0 | 1 | 0 | 2 | 0 | 1 | 0 | 3 | – | – | – | 0 | 0 | 0 | 0 | 2 | 3 | 0 | 0 | 0 |
| Vac/Vac Membrane | 125 | 299 | 47 | 57 | 77 | 60 | 58 | 77 | 32 | 47 | 38 | 61 | – | – | – | 84 | 103 | 80 | 7 | 36 | 5 | 0 | 0 | 1 |
| Unique Cell Count | 198 | 343 | 66 | 101 | 150 | 154 | 178 | 208 | 114 | 151 | 164 | 240 | 119 | 135 | 108 | 226 | 386 | 111 | 4 | 8 | 23 | |||
| Labelled Cell Count | 272 | 416 | 84 | 120 | 184 | 190 | 224 | 245 | 150 | 193 | 235 | 330 | 156 | 195 | 144 | 226 | 386 | 111 | 4 | 8 | 23 | |||
Yeast GFP Assignment
Protein Abundance
| Screen | WT1 | WT2 | WT3 | RAP60 | RAP140 | RAP220 | RAP300 | RAP380 | RAP460 | RAP540 | RAP620 | RAP700 | HU80 | HU120 | HU160 | rpd3Δ_1 | rpd3Δ_2 | rpd3Δ_3 | AF100 | AF140 | AF180 |
|---|---|---|---|---|---|---|---|---|---|---|---|---|---|---|---|---|---|---|---|---|---|
| Mean Cell GFP Intensity (1e-4) | 12.9 | 16.0 | 13.0 | 11.9 | 12.5 | 10.3 | 10.0 | 9.8 | 8.1 | 8.6 | 8.0 | 8.0 | – | – | – | 14.0 | 14.3 | 13.3 | – | – | – |
| Std Deviation (1e-4) | 2.6 | 3.1 | 2.6 | 2.3 | 2.2 | 2.2 | 2.0 | 2.0 | 1.6 | 1.7 | 1.6 | 1.6 | – | – | – | 3.3 | 3.1 | 3.9 | – | – | – |
| Intensity Change (Log2) | – | – | – | -0.13 | -0.05 | -0.34 | -0.39 | -0.41 | -0.69 | -0.6 | -0.71 | -0.7 | – | – | – | 0.1 | 0.13 | 0.03 | – | – | – |
Localization Change
| Localization | RAP60 | RAP140 | RAP220 | RAP300 | RAP380 | RAP460 | RAP540 | RAP620 | RAP700 | HU80 | HU120 | HU160 | rpd3Δ_1 | rpd3Δ_2 | rpd3Δ_3 |
|---|---|---|---|---|---|---|---|---|---|---|---|---|---|---|---|
| Cortical Patches | 0 | 0 | 0 | 0 | 0 | 0 | 0 | 0 | 0 | – | – | – | 0 | 0 | 0 |
| Bud | 0 | 0 | 0 | 0 | 0 | 0 | 0 | 0 | 0 | – | – | – | 0 | 0 | 0 |
| Bud Neck | 0 | 0 | 0 | 0 | 0 | 0 | 0 | 0 | 0 | – | – | – | 0 | 0 | 0 |
| Bud Site | 0 | 0 | 0 | 0 | 0 | 0 | 0 | 0 | 0 | – | – | – | 0 | 0 | 0 |
| Cell Periphery | 0 | 0 | 0 | 0 | 0 | 0 | 0 | 0 | 0 | – | – | – | 0 | 0 | 0 |
| Cytoplasm | -2.0 | -1.8 | -1.3 | -1.4 | -1.4 | -2.8 | 0 | 0 | 0 | – | – | – | -0.8 | -2.4 | -1.9 |
| Endoplasmic Reticulum | 0 | 0 | 0 | 0 | 0 | 0 | 0 | 0 | 0 | – | – | – | 0 | 0 | 0 |
| Endosome | 0 | 0 | 0 | 2.1 | 0 | 0 | 0 | 0 | 0 | – | – | – | 0 | 0 | 0 |
| Golgi | 0 | 0 | 0 | 0 | 0 | 0 | 0 | 0 | 0 | – | – | – | 0 | 0 | 0 |
| Mitochondria | 0 | 0 | 0 | 0 | 0 | 4.3 | 3.7 | 6.6 | 4.9 | – | – | – | 0 | 0 | 0 |
| Nucleus | 0 | 0 | 0 | 0 | 1.0 | 0 | 0 | 0 | 0.2 | – | – | – | 0 | 0 | 0 |
| Nuclear Periphery | 2.0 | 2.7 | 1.7 | 3.0 | 0.8 | 2.0 | 2.3 | 2.3 | 2.3 | – | – | – | -1.1 | 0.1 | -0.8 |
| Nucleolus | 0 | 0 | 1.7 | 0 | 1.9 | 3.7 | 2.9 | 3.1 | 2.9 | – | – | – | 0 | 0 | 0 |
| Peroxisomes | 0 | 0 | 0 | 0 | 0 | 0 | 0 | 0 | 0 | – | – | – | 0 | 0 | 0 |
| SpindlePole | 0 | 0 | 0 | 0 | 0 | 0 | 0 | 0 | 0 | – | – | – | 0 | 0 | 0 |
| Vacuole | -1.9 | -2.7 | -4.4 | -5.4 | -4.9 | -5.6 | -5.5 | -6.8 | -6.9 | – | – | – | -0.1 | 0.8 | 0.4 |
External localization resources
Images






























Protein Concentration and Protein Localization Data
| R1 | R2 | R3 | ||||||||||||||||
|---|---|---|---|---|---|---|---|---|---|---|---|---|---|---|---|---|---|---|
| G1 Pre-START | G1 Post-START | S/G2 | Metaphase | Anaphase | Telophase | G1 Pre-START | G1 Post-START | S/G2 | Metaphase | Anaphase | Telophase | G1 Pre-START | G1 Post-START | S/G2 | Metaphase | Anaphase | Telophase | |
| Concentration | 8.9828 | 9.73 | 9.1479 | 8.7592 | 7.1247 | 8.8707 | 8.6093 | 9.9466 | 8.6363 | 7.9299 | 6.5529 | 8.7189 | 8.5151 | 9.9924 | 9.0313 | 8.0154 | 7.0962 | 9.2457 |
| Actin | 0.0098 | 0.0002 | 0.0057 | 0.0017 | 0.0063 | 0.0002 | 0.0081 | 0.0008 | 0.0014 | 0.0037 | 0.005 | 0.0007 | 0.0063 | 0.0006 | 0.0014 | 0.0423 | 0.0263 | 0.0005 |
| Bud | 0.0006 | 0 | 0.0001 | 0.0001 | 0.0002 | 0 | 0.0003 | 0 | 0.0001 | 0.0001 | 0.0001 | 0 | 0.0002 | 0 | 0.0001 | 0.0005 | 0.0002 | 0 |
| Bud Neck | 0.0005 | 0.0001 | 0.0021 | 0.0001 | 0.001 | 0 | 0.0025 | 0.0001 | 0.0005 | 0.0002 | 0.0002 | 0.0001 | 0.0005 | 0.0001 | 0.0006 | 0.0017 | 0.0017 | 0.0001 |
| Bud Periphery | 0.0005 | 0 | 0.0003 | 0.0002 | 0.0004 | 0 | 0.0005 | 0.0001 | 0.0002 | 0.0004 | 0.0003 | 0 | 0.0003 | 0.0001 | 0.0002 | 0.0013 | 0.0003 | 0 |
| Bud Site | 0.0034 | 0 | 0.0037 | 0.0001 | 0.0002 | 0 | 0.0029 | 0.0001 | 0.0003 | 0.0002 | 0.0004 | 0 | 0.0012 | 0.0001 | 0.0021 | 0.0008 | 0.0006 | 0 |
| Cell Periphery | 0.0003 | 0 | 0.0003 | 0 | 0.0001 | 0 | 0.0002 | 0 | 0.0003 | 0.0001 | 0.0002 | 0 | 0.0001 | 0 | 0.0004 | 0.0004 | 0.0001 | 0 |
| Cytoplasm | 0.0104 | 0.0026 | 0.0013 | 0.0025 | 0.0019 | 0.0002 | 0.0015 | 0.0003 | 0.0012 | 0.0003 | 0.0074 | 0.0003 | 0.006 | 0.0008 | 0.0005 | 0.0087 | 0.0024 | 0.0017 |
| Cytoplasmic Foci | 0.0102 | 0.0001 | 0.0037 | 0.001 | 0.0068 | 0.0002 | 0.0097 | 0.0014 | 0.002 | 0.0038 | 0.0458 | 0.0005 | 0.0188 | 0.0002 | 0.0024 | 0.0032 | 0.0282 | 0.0008 |
| Eisosomes | 0.0002 | 0 | 0.0001 | 0 | 0.0001 | 0 | 0.0002 | 0 | 0.0008 | 0.0001 | 0.0003 | 0 | 0.0002 | 0 | 0.0001 | 0.0005 | 0.0001 | 0 |
| Endoplasmic Reticulum | 0.0042 | 0.0023 | 0.0049 | 0.006 | 0.0055 | 0.001 | 0.007 | 0.0058 | 0.0055 | 0.0147 | 0.0058 | 0.0035 | 0.0076 | 0.0058 | 0.0043 | 0.013 | 0.0034 | 0.0019 |
| Endosome | 0.0208 | 0.0007 | 0.0148 | 0.0051 | 0.0181 | 0.0027 | 0.0111 | 0.0122 | 0.0114 | 0.0213 | 0.051 | 0.0034 | 0.0305 | 0.0011 | 0.0035 | 0.0239 | 0.0383 | 0.0023 |
| Golgi | 0.0087 | 0.0001 | 0.0036 | 0.0003 | 0.0023 | 0.0011 | 0.0026 | 0.0016 | 0.0008 | 0.0347 | 0.0116 | 0.0012 | 0.0038 | 0.0004 | 0.0012 | 0.0038 | 0.0226 | 0.0017 |
| Lipid Particles | 0.0182 | 0.0003 | 0.0143 | 0.0007 | 0.0204 | 0.0031 | 0.0115 | 0.0029 | 0.0048 | 0.0126 | 0.0777 | 0.0036 | 0.0238 | 0.0045 | 0.0124 | 0.0317 | 0.0275 | 0.0022 |
| Mitochondria | 0.0096 | 0.0003 | 0.0018 | 0.0009 | 0.0141 | 0.0002 | 0.0077 | 0.0009 | 0.0046 | 0.0032 | 0.0376 | 0.0004 | 0.0076 | 0.008 | 0.0011 | 0.0409 | 0.0046 | 0.011 |
| None | 0.0033 | 0.0001 | 0.0004 | 0.0003 | 0.0012 | 0 | 0.0036 | 0.0001 | 0.0006 | 0.0004 | 0.0036 | 0.0001 | 0.0135 | 0.0001 | 0.0002 | 0.0122 | 0.0009 | 0.0001 |
| Nuclear Periphery | 0.8515 | 0.8892 | 0.8697 | 0.9013 | 0.8358 | 0.9564 | 0.8832 | 0.9118 | 0.8971 | 0.8622 | 0.6984 | 0.9644 | 0.8066 | 0.8895 | 0.8864 | 0.691 | 0.7344 | 0.9496 |
| Nucleolus | 0.0031 | 0.0056 | 0.0076 | 0.0011 | 0.0028 | 0.0004 | 0.0011 | 0.0025 | 0.0006 | 0.0004 | 0.0014 | 0.0002 | 0.0027 | 0.0009 | 0.0011 | 0.0039 | 0.0006 | 0.0002 |
| Nucleus | 0.0113 | 0.0752 | 0.0327 | 0.0386 | 0.0362 | 0.0198 | 0.0076 | 0.0156 | 0.0124 | 0.0103 | 0.0031 | 0.0077 | 0.024 | 0.0612 | 0.045 | 0.097 | 0.0283 | 0.0152 |
| Peroxisomes | 0.0042 | 0 | 0.0015 | 0.0001 | 0.0004 | 0 | 0.0035 | 0.0001 | 0.001 | 0.0003 | 0.0238 | 0.0001 | 0.0061 | 0 | 0.0076 | 0.0012 | 0.0459 | 0.0014 |
| Punctate Nuclear | 0.0073 | 0.0037 | 0.0023 | 0.0072 | 0.0167 | 0.0021 | 0.0086 | 0.012 | 0.0022 | 0.0015 | 0.0081 | 0.0014 | 0.0158 | 0.0018 | 0.0063 | 0.0043 | 0.0208 | 0.0011 |
| Vacuole | 0.0031 | 0.001 | 0.0032 | 0.0021 | 0.0046 | 0.0005 | 0.0036 | 0.0013 | 0.0149 | 0.0026 | 0.0025 | 0.0005 | 0.005 | 0.0013 | 0.0023 | 0.0043 | 0.0014 | 0.0008 |
| Vacuole Periphery | 0.0188 | 0.0183 | 0.026 | 0.0302 | 0.0251 | 0.012 | 0.0229 | 0.0302 | 0.0372 | 0.027 | 0.0157 | 0.0118 | 0.0194 | 0.0236 | 0.0209 | 0.0133 | 0.0115 | 0.0093 |
Sequencing Data
| R1 | R2 | |||||||||
|---|---|---|---|---|---|---|---|---|---|---|
| G1 Post-START | S/G2 | Metaphase | Anaphase | Telophase | G1 Post-START | S/G2 | Metaphase | Anaphase | Telophase | |
| Gene Expression | 31.8761 | 25.7554 | 30.0906 | 39.2945 | 40.9314 | 25.1192 | 31.3049 | 38.5178 | 29.7686 | 39.3365 |
| Translational Efficiency | 1.3739 | 1.693 | 1.2939 | 0.9348 | 1.0235 | 1.4554 | 1.2883 | 0.9066 | 1.301 | 1.1154 |
Hit Data
| Dataset | Hit |
|---|---|
| Protein Concentration | ✔ |
| Protein Localization | ✘ |
| Gene Expression | ✘ |
| Translational Efficiency | ✘ |
Endocytosis
| Temp | Actin Patch (Sac6-tdTomato) | Cortical Patch (Sla1-GFP) | Late Endosome (Snf7-GFP) | Vacuole (Vph1-GFP) |
|---|---|---|---|---|
| 37℃ | ||||
| RT |
Cell Cycle Omics
CYCLoPs (Mex67-GFP)
| Gene / Allele | Actin Patch (Sac6-tdTomato) | Cortical Patch (Sla1-GFP) | Late Endosome (Snf7-GFP) | Vacuole (Sac6-tdTomato) |
|---|
| Gene | Images |
|---|
| Gene | Images |
|---|
Images are not yet available
Images are not yet available